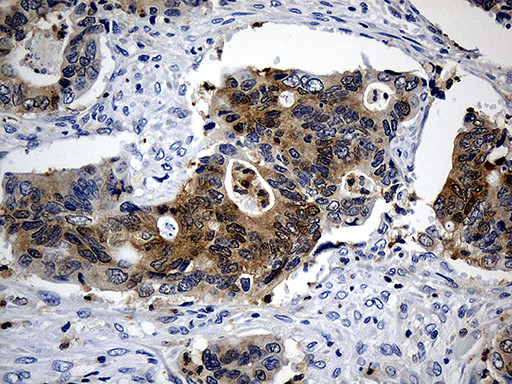
SULT1A3 Antibody in Immunohistochemistry (Paraffin) (IHC (P))

Search
OriGene
SULT1A3 Monoclonal Antibody (OTI5E9), TrueMAB™
{{$productOrderCtrl.translations['antibody.pdp.commerceCard.promotion.promotions']}}
{{$productOrderCtrl.translations['antibody.pdp.commerceCard.promotion.viewpromo']}}
{{$productOrderCtrl.translations['antibody.pdp.commerceCard.promotion.promocode']}}: {{promo.promoCode}} {{promo.promoTitle}} {{promo.promoDescription}}. {{$productOrderCtrl.translations['antibody.pdp.commerceCard.promotion.learnmore']}}
产品信息
TA811128
种属反应
宿主/亚型
分类
类型
克隆号
抗原
偶联物
形式
浓度
规格
纯化类型
保存液
内含物
保存条件
运输条件
靶标信息
Sulfotransferase enzymes catalyze the sulfate conjugation of many hormones, neurotransmitters, drugs, and xenobiotic compounds. These cytosolic enzymes are different in their tissue distributions and substrate specificities. The gene structure (number and length of exons) is similar among family members. This gene encodes a phenol sulfotransferase with thermolabile enzyme activity. Four sulfotransferase genes are located on the p arm of chromosome 16; this gene and SULT1A4 arose from a segmental duplication. This gene is the most centromeric of the four sulfotransferase genes. Exons of this gene overlap with exons of a gene that encodes a protein containing GIY-YIG domains (GIYD1). Multiple alternatively spliced variants that encode the same protein have been described.
仅用于科研。不用于诊断过程。未经明确授权不得转售。
篇参考文献 (0)
生物信息学
蛋白别名: Aryl sulfotransferase 1A3/1A4; Catecholamine-sulfating phenol sulfotransferase; CSPS; dopamine-specific sulfotransferase; HAST3; M-PST; Monoamine-sulfating phenol sulfotransferase; monoamine-sulfating phenosulfotransferase; phenol sulfotransferase 1A5; Placental estrogen sulfotransferase; ST1A3; sulfokinase; Sulfotransferase 1A3; Sulfotransferase 1A3/1A4; Sulfotransferase 1A4; sulfotransferase family, cytosolic, 1A, phenol-preferring, member 3; Sulfotransferase, monoamine-preferring; thermolabile (monoamine, M form) phenol sulfotransferase; Thermolabile phenol sulfotransferase; TL-PST; unnamed protein product
基因别名: HAST; HAST3; M-PST; ST1A3; ST1A3/ST1A4; ST1A4; ST1A5; STM; SULT1A3; TL-PST
UniProt ID: (Human) P0DMM9
Entrez Gene ID: (Human) 6818